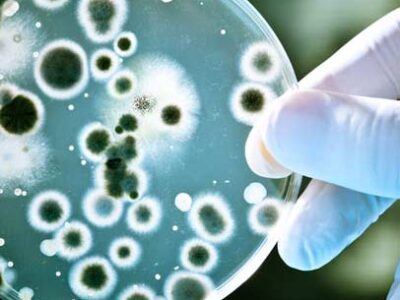
microbiologie_appliquee_aux_produits_cosmetiques-3

Les produits d’entretiens font partie des biens de consommation qui rendent notre vie quotidienne plus agréable, mais sont-ils surs et efficaces ?
SECULAB aide les fabricants à garantir aux consommateurs un achat en toute confiance de milliers de biens de consommation présents sur le marché.
Aujourd’hui, tous les détergents doivent répondre à des normes de qualité, d’efficacité et de sécurité toujours plus strictes.
Nos services d’analyses précis et compétitifs peuvent vous aider à garantir que vos produits répondent aux attentes des consommateurs et aux exigences réglementaires.
SECULAB effectue des analyses physico-chimiques et microbiologiques permettant de garantir la qualité et la conformité de tous vos produits.
Analyses Microbiologiques :
- Germes totaux
- Entérobactéries
- Escherichia coli
- Staphylococcus aureus
- Pseudomonas aeruginosa
- Levures
- Moisissures
- Pouvoir bactéricide
Analyse physico-chimique :
Contenance, poids, pH, densité, matière active, teneur en eau, extrait sec, Degré chlorométrique…